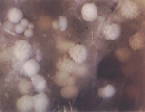

淡水海綿 多細胞動物の始まりを生きる
カットごとの記録
最終更新: 2000.11.20.
はじめに:
海綿カットごとの記録
この作品ではノーマルスピード(real time)で撮影したカットと、時間を短縮して撮影(タイムラプス撮影)しているカットが混在しています。また現象によってフレームとフレームの間隔(インターバル)を変化させています。さらに、1つのカットでも見易い映像になるようにインターバルを次第に変えていっている場合もあります。
このデータ集では画像1フレームごとのインターバルを 1f/ x sec (or min ) と記しました。ビデオは30フレーム で1秒です。(NTSC方式走査線数525本)
タイムラプス撮影にはソニー製 CRVdisc追記型光デイスクレコーダーを拝借し使用させていただきました。この機械では、それまで撮影した画像をタイムラプス撮影中に再生する事ができます。カイメンが変化していく様子を 監修してくださっていた渡辺洋子先生に撮影の現場で見ていただき、指示を仰ぐ事が出来ました。
顕微鏡撮影に際しては、しばしばビデオ(テレビ)カメラヘッドを顕微鏡にとりつける専用のアダプターを使用しますが、今回の撮影では、このアダプターを使用していません。接眼レンズとカメラヘッドは切り離されています。カメラ自体が顕微鏡からの結像面に対してxyz軸の3方向に動く事が出来るようにしてあるのです。これは、被写体の強調した部分をピックアップするためです。またこうすることにより、高拡大された画面に、撮影機材から発生する機械的な振動の影響を防ぐ効果もあります。
ビデオカメラヘッドの機械的振動はフィルムカメラより遙かに少ないのですがカムコーダータイプでは、どうしても振動は皆無となりません。
結像面からカメラまでの位置が変化しているため、画面の拡大率にも変化があります。本来ならば、一カットごとにスケールを撮影するべきだったのですが、生きた試料をできるだけ速やかに記録することを優先したため、すべてにおいてスケールを入れる事は出来ませんでした。そのため、このデータ集には使用したレンズを示しております。スケールの記録があった場合には、具体的な画面横軸の幅(画面幅)をしめしました。
なお、文面中で画面幅という言葉は、画面横軸の端から端までの長さを意味しています。この記録がある場合には、画面幅 x mm として示しています。
このビデオの中で観察に使われている海綿の種類は最後の実験を除いてカワカイメンです。カワカイメンの芽球の大きさの平均は約 0.5mmです。スケールの参考にしてください。
顕微鏡を使用した映像に関しましては、(対物レンズの種類・倍率) x (対眼レンズの倍率)の順に書いてあります。
接写レンズ(下記に示してあります)を使用した映像に関しましては、接写レンズの種類のみを書いてあります。
それぞれのおおよその画面幅は以下のとおりです。
・ ルミナール16mm 画面幅 0.7~2mm
・ ルミナール25mm 画面幅 1mm前後
・ ルミナール40mm 画面幅 3~4mm
・ ルミナール63mm 画面幅 ~3cm
・ ズマール80mm 画面幅 ~3cm
・ テッソバール 画面幅 0.7~2mm
ルミナール、テッソバールは、カール・ツァイス社、ズマールは、エルンスト・ライツ社の接写レンズです。主に使用した顕微鏡はインヴェルトスコープDという1970年代中期に製作された、カール・ツァイス社の非常に単純な構造の倒立顕微鏡です。
もともと低倍率のプランクトンスコープというプランクトン観察用顕微鏡が進化したもので、対物X60X100の微分干渉顕微鏡として使用可能ではありますが、カールツァイス社の技術者からは、こんな高倍率の記録をあれでやってしまったのか?!と、あきれられたことがあります。しかし、単純な構造のため、撮影と言う用途には実に使いやすく、最近では生産が打ちきられて部品の入手が、ドイツ本国でもままならないのは、誠に遺憾です。
撮影に用いた海綿の殆どは「サンドイッチ培養法」で培養したものです。海綿の厚さを薄くすることで、断面的な発生を観察したり、中膠内の細胞の動きや襟細胞の鞭毛の動きをはっきりと見ることが出来ました。
ご質問やご意見は、下記アドレスまでお願いいたします。皆様のご要望に応えて、データを充実させていきたいと思っております。
162-0843 東京都新宿区市谷田町2-7-302
東京シネマ新社
電話:03-3269-6751 ファックス:03-3269-6746
お問い合わせ先:
海綿の内容に関わること
鈴木由紀 e-mail: y-suzuki@TokyoCinema.net
作品の利用に関わること
岡田一男 e-mail: info@TokyoCinema.net

1:DIC6.3 X5 1f/24sec

2:ルミナール40mm 画面幅 3mm 1f/3min

3:三重県北山川の風景

4:北山川に生息しているヌマカイメンの水中映像

5:茨城県 霞が浦への新利根川の流入口

6:霞が浦に生息しているカワカイメン。一本の杭に2つのカワカイメンがついている。2つともカワカイメンだが中央部分に線が見える。

7:ルミナール40mm 1f/5sec

8:模式図

9:模式図

10:模式図

11:ズマール80mm

12:ルミナール40mm 画面幅 4mm 1f/5~60sec

13:DIC16 X8 1f/0.2sec

14:DIC6.3 X 8 1f/6sec

15:DIC16 X 8 1f/20sec

16:DIC16 X 8 1f/0.2sec

17:ルミナール40mm 画面幅 3mm 1f/30~60sec

18:ルミナール40mm 画面幅 3mm 1f/2min

19:ルミナール40mm 画面幅 4mm 1f/3min (no.12の続き)

20:霞が浦のカワカイメン

21:霞が浦のカワカイメン(コンクリートの壁に付いている)

22:霞が浦での採集(1月)

23:芽球がたくさんついた枝

24:ルミナール

25:ルミナール40mm 画面幅 3mm 1f/90~120sec(横から見ている)

26:DIC6.3 X8 1f/6sec

27:DIC16 X 8 1f/6sec

28:暗視野2.5 X 8 1f/42sec

29:テッソバール 画面幅 3mm 1f/1sec

30:テッソバール 画面幅 3~12mm 1f/1sec

31:DIC16 X 8 real time 食べさせている餌は芽球の中の細胞(貯蔵細胞)から作っている。

32:Ph16 X 5 real time

33:DIC40 X 8 real time

34:DIC40 X 8 1f/6sec

35:

36:DIC40 X 8 real time

37:DIC40 X 8 real time

38:テッソバール 1f/1sec (横から見ている)

39:暗視野2.5 X 5 1f/30sec

40:テッソバール

41:Ph10 X 5 1f/6sec

42:DIC16 X 8 1f/6sec

43:DIC63 X 8 1f/6sec

44:DIC40 X 8 real time

45:DIC100 X 8 real time

46:模式図

47:DIC16 X 10 1f/6sec

48:Ph25 X 5 1f/6sec

49:DIC40 X 8 1f/6sec

50:DIC40 X 10 1f/2sec 観察が始まって分裂が終わるまでは約17分

51:DIC6.3 X 8 1f/6sec 観察が始まって分裂が終わるまでは約7分

52:DIC40 X 8 1f/6sec

53:DIC16 X 8 1f/6sec

54:DIC16 X 10 1f/6sec

55:DIC6.3 X 8 1f/6sec

56:DIC6.3 X 5 1f/6sec

57:テッソバール

58:ルミナール40mm 1f/5sec このカットの実際の長さは22分30秒

59:Ph25 X 10 1f/6sec

60:ルミナール40mm 1f/10sec

61:ズマール80mm real time

62:ルミナール63mm real time
63:ルミナール25mm real time

64:ルミナール16mm real time

65:ルミナール63mm real time

66:ルミナール63mm real time

67:ルミナール63mm real time

68:ルミナール40mm real time

69:ルミナール

70:ルミナール40mm

71:2.5 X 8 1f/20sec 幼生を横から撮影。実際の撮影時間は230分(3時間50分)

72:DIC6.3 X 8 1f/20sec 実際の撮影時間は160分(2時間30分)

73:DIC6.3 X 8 1f/20sec 実際の撮影時間は120分(2時間)

74:DIC16 X 8 1f/10sec

75:DIC6.3 X 8 1f/25sec

76:DIC16 X 8 1f/6sec

77:埼玉県久喜市で撮影

78:ズムール80mm

79:ルミナール63mm 1f/2min 実際の撮影時間は3598分(2日11時間58分)

80:DIC6.3 X 8 1f/6sec

81:DIC6.3 X 8 1f/6sec

82:DIC16 X 8 1f/6sec

83:DIC6.3 X 8 1f/6sec

84:DIC16 X 8 1f/6sec
細胞が動いている時間(動)とまったく動かない時間(静)があった。
この作品の中では、静(222秒)、動(2688秒)、静(282秒)、動(2880秒)、静(126秒)、動の順に細胞は動いていた。
括弧の中の秒数は実際の秒数

85:DIC16 X 10 1f/6sec

86:ルミナール40mm 1f/3sec

87:ルミナール25mm 画面幅1.8mm 1f/2min

88:ルミナール63mm 1f/2min

89:ズマール80mm

90:

91:

92:Ph10 X 5

93:DIC100 X 8 1f/6sec

94:DIC100 X 8 1f/6sec

95:DIC64 X 8 1f/6sec

96:DIC100 X 8 1f/6sec

97:Ph25 X 8 1f/3sec

98:DIC16 X 8 1f/6sec

99:DIC16 X 8 1f/6sec

100:DIC16 X 8 1f/6sec

101:DIC6.3 X 8 1f/10sec

102:6.3 X 8 1f/10sec

103:DIC16 X 8 1f/10sec

104:DIC16 X 8 1f/10sec

105:DIC16 X 8 1f/10sec

106:暗視野2.5 X 8 1f/24sec

107:Ph16 X 8 1f/6sec

108:DIC6.3 X 8 1f/10sec

109:ルミナール40mm 画面幅4mm 1f/2min

110:Ph25 X 8 画面幅130~150μm 1f/10sec

111:DIC16 X 8 1f/10sec

112:Ph16 X 8 1f/10sec

113:暗視野25 X 8 1f/10sec

114:DIC16 X 8 1f/10sec

115:暗視野25 X 8 1f/10sec

116:ルミナール40mm 1f/2min

117:DIC16 X 8 1f/6sec

118:Ph16 X 8 1f/10sec

119:暗視野6.3 X 8 1f/20sec

120:暗視野6.3 X 8 1f/25~30sec

121:
最終更新日: 2000.11.20.
return to the TOP PAGE
return to the Sponge Top